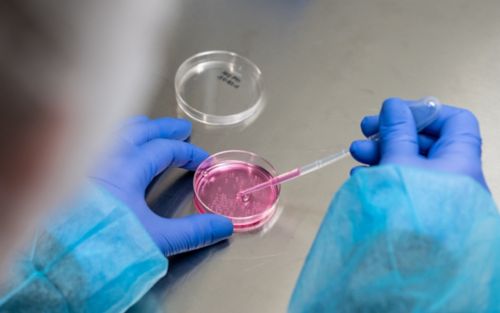

St. Jude Family of Websites
Explore our cutting edge research, world-class patient care, career opportunities and more.
St. Jude Children's Research Hospital Home

- Fundraising
St. Jude Family of Websites
Explore our cutting edge research, world-class patient care, career opportunities and more.
St. Jude Children's Research Hospital Home

- Fundraising
Xiaoyu Chen Lab
Genetic approaches and 3D models for human brain disorders
About the Chen Lab
The Chen Lab investigates the genetic mechanisms underlying pediatric neurodevelopmental disorders. Building on advances in multi-level in vitro and in vivo 3D cellular systems, we aim to investigate how disease-associated genetic variants contribute to human brain development and to leverage these insights to develop data-driven therapeutic strategies. Our research program integrates genetic engineering, functional omics, and stem cell-derived (organoid) models to study pediatric neurological disorders. Ultimately, we seek to identify the cellular and molecular modifiers that drive disease initiation and progression, thereby enabling more effective therapeutic discovery.
Our research summary
Alternative splicing allows a single gene to produce multiple transcripts, efficiently and exponentially enhancing protein diversity, and could drive species difference and tissue diversity. We previously showed that, early in human development, the CACNA1C gene predominantly expressed the exon 8A isoform, and switched to the exon 8 isoform, a transition that is regulated by the splicing machinery. The Timothy syndrome-associated variant in CACNA1C significantly enhances the 8A isoform contributing to disease progression. We hypothesized that switching expression from exon 8A to exon 8 could serve as a therapeutic strategy. Through antisense oligonucleotide (ASO) “walking” screening in Timothy syndrome brain organoids, we identified candidates that reduced exon 8A and corrected the disease-related calcium channel defects. These ASOs also rescued cortical interneuron migration in organoids and, after in vivo transplantation, showed functional rescue in our model systems. We aim to apply similar approaches to a wide array of rare pediatric neurological disorders.

Advancing human model systems
While current organoid technologies effectively model early stages of brain development, they are limited in their ability to capture later-onset disease. To address this, one branch of our research focuses on improving human neural models by enhancing neuronal maturation and reproducibility.
As we develop organoid systems that are more mature and stable, we can extend human-based modeling past prenatal developmental stages and begin to investigate neurological disorders that emerge in childhood.
Developing mechanism-based therapeutics
A central focus of our lab is to translate mechanistic insights into therapeutic strategies. We are advancing ASO strategies to correct abnormal RNA splicing and counteract gain-of-function disease variants. ASOs have demonstrated clinical success in disorders such as spinal muscular atrophy, and their established safety profile makes them a promising platform for treating rare neurological diseases.

Our group is also looking into delivery approaches, including AAV-based vectors, to achieve stable gene modulation in the central nervous system. We are working to design and test ASO and viral constructs directly in human brain organoid models before moving toward preclinical studies, allowing us to pinpoint the most effective and safest strategy for each genetic background.
Collaborative approach
Our lab is part of the Center for Pediatric Neurodegenerative Research (CPNDR) within the Pediatric Translational Neuroscience Initiative (PTNI) at St. Jude, which fosters close collaboration across bench research and clinical teams. We work alongside colleagues studying childhood epilepsies and other neurodevelopmental disorders to refine disease models and evaluate emerging therapeutic strategies.
This collaborative network, combined with the exceptional resources and multidisciplinary environment at St. Jude, empowers our lab to advance the discovery and development of new treatments for rare neurological diseases.
The team
The Chen Lab has a growing, energetic team of researchers committed to advancing discovery and development of therapeutics for rare neurological disorders.
-
View Details
Elizabeth Duecker
Graduate Student
-
View Details
Kilsoo Jeon, PhD
Scientist
-
View Details
Jyotsna Joshi, PhD
Postdoctoral Research Associate

Dr. Xiaoyu Chen earned her BS in Medicine and MS in Neurology from Hebei Medical University, China, and completed a PhD in Molecular Biology at Leiden University, the Netherlands. Following her doctoral work on genome engineering and CRISPR-based gene-editing strategies, Dr. Chen pursued postdoctoral training in neuroscience at Stanford University, where she combined human brain organoids, stem cell engineering and advanced molecular tools to study disorders such as Timothy syndrome.
Dr. Chen is currently an Assistant Member in the Department of Genomic and Translational Neuroscience, where her research focuses on understanding the biological mechanisms of and developing therapies for pediatric neurological disorders. She is affiliated with the Center for Pediatric Neurological Disease Research (CPNDR) within the Pediatric Translational Neuroscience Initiative (PTNI) at St. Jude.
Dr. Chen’s research integrates genome editing, imaging, and single-cell sequencing to uncover the molecular and cellular mechanisms underlying early-onset brain disorders. She has developed targeted antisense oligonucleotide (ASO) therapies capable of rescuing disease phenotypes both in vitro and in vivo, demonstrating the potential for precision medicine approaches in neurodevelopmental diseases. Her work bridges basic science and translational research, with the goal of identifying therapeutic strategies that address the root causes of devastating brain disorders in children.
Contact us
Xiaoyu Chen, PhD
Center for Pediatric Neurological Disease Research
Room M3418
St. Jude Children’s Research Hospital

Memphis, TN, 38105-3678 USA GET DIRECTIONS


